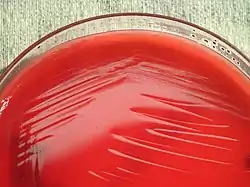

Kingella kingae
Kingella kingae es una especie de bacteria gramnegativa de la familia Neisseriaceae.[2] Aislado por primera vez en 1960 por Elizabeth O. King, no fue reconocida como una causa significativa de infección en niños pequeños hasta la década de 1990, cuando las técnicas de cultivo habían mejorado lo suficiente como para ser reconocida. Es más conocida como una causa de artritis séptica, osteomielitis, espondilodiscitis, bacteriemia y endocarditis, y con menos frecuencia infecciones del tracto respiratorio inferior y meningitis..[3] Forma parte del grupo HACEK, un conjunto de bacterias que pertenecen a microbiota oral o del tracto respiratorio superior con tendencia a causar endocarditis.[4]
| Kingella kingae | ||
|---|---|---|
![]() Colonias de Kingella kingae en agar sangre | ||
| Taxonomía | ||
| Dominio: | Bacteria | |
| Filo: | Pseudomonadota | |
| Clase: | Betaproteobacteria | |
| Orden: | Neisseriales | |
| Familia: | Neisseriaceae | |
| Género: | Kingella | |
| Especie: |
Kingella kingae (Henriksen & Bøvre 1968) Henriksen & Bøvre 1976 | |
| Sinonimia | ||
Taxonomía
Aislada por primera vez en 1960 por Elizabeth O. King, de quien toma el nombre, fue clasificada inicialmente dentro de Moraxella,[2][5] pero transferida en 1976 a Kingella, un nuevo género.[2][6] Aunque pertenece a la familia Neisseriaceae, su relación filogenética con el resto de sus integrantes es distante.[2]
Microbiología
K. kingae es una especie gramnegativa, anaerobia facultativa y con morfología de cocobacilo. Produce un anillo débil de β-hemólisis en los medios de cultivo con sangre, es inmóvil y no produce endosporas. Es oxidasa-positiva, pero negativa para las pruebas de la catalasa, indol y ureasa.[7]
Tiene requerimientos nutricionales exigentes a la hora de ser cultivada. Crece en agar sangre, agar chocolate y agar GC, pero no en los medios de MacConkey o de Krigler.[7]
Referencias
- «Kingella kingae». NCBI Taxonomy (en inglés). Consultado el 25 de abril de 2021.
- Yagupsky, 2015, p. 55.
- Yagupsky, 2004, p. 358.
- Sharara et al., 2016, pp. 539-540.
- Henriksen y Bøvre, 1968, p. 377.
- Henriksen y Bøvre, 1976, pp. 447-450.
- Adebiyi, Ebenezer O.; Ayoade, Folusakin (10 de julio de 2020). «Kingella kingae». NCBI (en inglés). StatPearls. Consultado el 26 de abril de 2021.
- Partes de este artículo contienen texto de «Kingella kingae», una reseña de StatPearls obra de Ebenezer O. Adebiyi y Folusakin Ayoade publicada bajo licencia Creative Commons Atribución 4.0 Internacional (CC-BY 4.0).
Bibliografía
- Henriksen, S. D.; Bøvre, K. (1968). «Moraxella kingii sp.nov., a Haemolytic, Saccharolytic Species of the Genus Moraxella». Journal of General Microbiology (en inglés) 51 (3): 377-385. PMID 5185818. doi:10.1099/00221287-51-3-377. Consultado el 25 de abril de 2021.
- ——; Bøvre, K. (1976). «Transfer of Moraxella kingae Henriksen and Bøvre to the Genus Kingella gen. nov. in the Family Neisseriaceae». International Journal of Systematic Bacteriology (en inglés) 26 (4): 447-450. PMID 5185818. doi:10.1099/00207713-26-4-447. Consultado el 25 de abril de 2021.
- Sharara, Sima L.; Tayyar, Ralph; Kanafani, Zeina A.; Kanj, Souha S. (2016). «HACEK endocarditis: a review». Expert Review of Anti-infective Therapy (en inglés) 14 (6): 539-545. PMID 27124204. doi:10.1080/14787210.2016.1184085.
- Yagupsky, Pablo (2004). «Kingella kingae: from medical rarity to an emerging paediatric pathogen». The Lancet Infectious Diseases (en inglés) 4 (6): 358-367. PMID 15172344. doi:10.1016/S1473-3099(04)01046-1.
- —— (2015). «Kingella kingae: Carriage, Transmission, and Disease». Clinical Microbiology Reviews (en inglés) 28 (1): 54-79. PMC 4284298. PMID 25567222. doi:10.1128/CMR.00028-14. Consultado el 25 de abril de 2021.